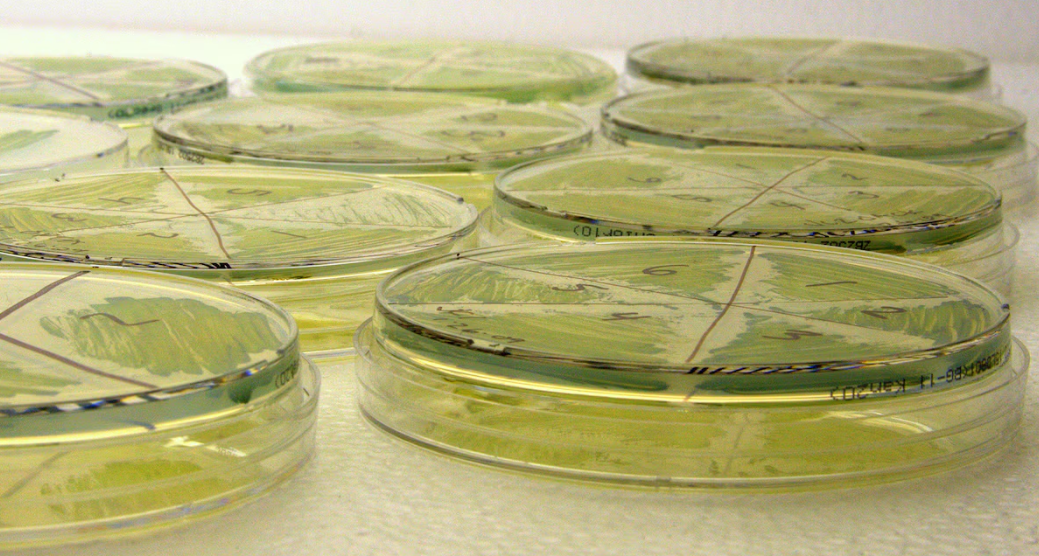

La ingeniería genética dio un salto significativo con la creación de un microorganismo eucariota en levadura. La revista Esquire informó sobre la tecnología que podría revolucionar la producción de fármacos y terapias innovadoras
La posibilidad de diseñar organismos vivos adaptados a necesidades específicas dio un paso significativo con la creación del primer genoma eucariota completamente sintético. Este desarrollo, liderado por Hugh Goold, biólogo sintético de la Universidad Macquarie en Australia, marca una hazaña en la ingeniería genética, al permitir la reconfiguración de organismos para mejorar su funcionalidad y resistencia. Debido a esto, la revista Esquire realizó un informe sobre el avance. Hasta el momento, la síntesis de genomas completos se había limitado a procariotas, organismos unicelulares sin núcleo. La nueva investigación logró ensamblar por completo el genoma de un organismo eucariota, caracterizado por poseer núcleo y orgánulos diferenciados, lo que representa un desafío mayor en términos de complejidad genética. Esta evolución abre la puerta a la creación de seres vivos con características personalizadas, con aplicaciones potenciales en la producción de alimentos, biotecnología y medicina.Como parte del “Proyecto Sc2.0″, los investigadores eligieron la Saccharomyces cerevisiae, una levadura utilizada desde hace siglos en la fabricación de cerveza, vino y pan, para reconstruir su genoma con modificaciones estratégicas. El rediseño de esta especie, llevado a cabo durante una década, tuvo como principal objetivo mejorar su capacidad de producción de esporas y reducir su propensión a mutaciones espontáneas. Este proceso de optimización genética permite que la levadura tenga un crecimiento más estable, y también le otorga propiedades que pueden hacerla más resistente a enfermedades y cambios ambientales. En un contexto de crisis climática y desafíos en la seguridad alimentaria, estas modificaciones podrían garantizar la producción eficiente y sostenible de insumos básicos.
Para ensamblar el genoma sintético de Saccharomyces cerevisiae, los científicos partieron de cepas en las que ya se habían insertado fragmentos de ADN artificial. A partir de ahí, aplicaron un método de retrocruzamiento, técnica que consiste en cruzar células progenitoras con características genéticas distintas para generar descendientes híbridos. A su vez, estos fueron nuevamente cruzados con sus células progenitoras con el fin de estabilizar los rasgos deseados. El biólogo Goold y su equipo identificaron que la cepa con el cromosoma sintético SynXVI presentaba dificultades de crecimiento y alta frecuencia de mutaciones. Para corregir estos problemas, realizaron nuevas rondas de retrocruzamiento, lo que les permitió detectar fallos en la colocación de marcadores genéticos. Estas secuencias, empleadas para identificar genes y cromosomas dentro del genoma, interferían con el funcionamiento celular de la levadura.Además de estos ajustes, los investigadores implementaron herramientas de edición genética como CRISPR D-BUGS, diseñadas para corregir errores en regiones específicas del ADN. Una de las soluciones clave para mejorar la estabilidad de SynXVI fue optimizar sus condiciones de crecimiento, permitiendo que la levadura utilizara glicerol como fuente de carbono.
El futuro de la genómica sintética: aplicaciones y desafíos
El desarrollo del primer genoma eucariota sintético representa un punto de partida para la aplicación de la biología sintética en múltiples ámbitos. Más allá de la optimización de la levadura, esta tecnología abre nuevas posibilidades en la ingeniería de microorganismos utilizados en procesos industriales sostenibles. La capacidad de modificar genomas completos podría mejorar la eficiencia de microorganismos empleados en la producción de biocombustibles, fármacos y materiales biodegradables.
“La tecnología de la genómica sintética puede ayudar a asegurar la cadena de suministro en situaciones futuras en las que el cambio climático, nuevas pandemias mundiales y conflictos pongan en peligro la disponibilidad de materias primas críticas”, señalaron los autores del estudio.
Si bien el diseño de microorganismos sintéticos con aplicaciones industriales es una realidad, el siguiente desafío será ampliar estos avances a organismos más complejos. Aunque la creación de genomas artificiales de mamíferos aún parece lejana, los expertos consideran que la biología sintética continuará evolucionando hasta alcanzar nuevos hitos en el diseño y modificación de la vida.

No hay comentarios:
Publicar un comentario